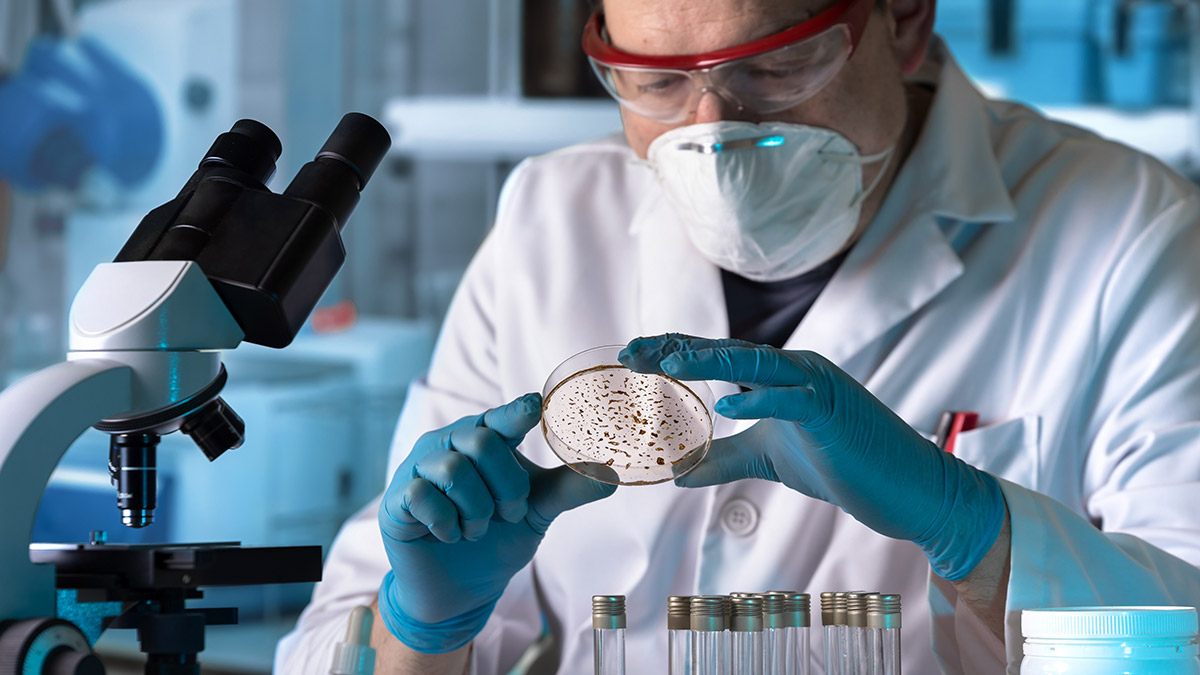
Yeditepe Üniversitesi Hastaneleri Enfeksiyon Hastalıkları ve Klinik Mikrobiyoloji uzmanı Prof. Dr. Meral Sönmezoğlu, antibiyotiklerin gereksiz kullanımının 21. yüzyılda en büyük sağlık tehlikesi olduğunu söyledi.

Yeditepe Üniversitesi Hastaneleri Enfeksiyon Hastalıkları ve Klinik Mikrobiyoloji uzmanı Prof. Dr. Meral Sönmezoğlu, antibiyotiklerin gereksiz kullanımının 21. yüzyılda en büyük sağlık tehlikesi olduğunu söyledi.
Antibiyotiklerin tıp biliminin insanlık yararına yaptığı en büyük buluşlardan biri olduğunu hatırlatan Enfeksiyon Hastalıkları ve Klinik Mikrobiyoloji uzmanı Prof. Dr. Meral Sönmezoğlu, antibiyotiklerin uygun kullanımı dışında gereksiz ve fazla kullanımının 21. yüzyılda en büyük sağlık tehlikesi olan antimikrobiyal direncini yarattığını ve Dünya Sağlık Örgütü’nün de (DSÖ) bu konuda alarm zillerini çalmaya başladığını söyledi.
Global anlamda çok büyük bir sorun olan ve gelecek için de çok daha büyük riskler barındıran antimikrobiyal direnç konusuna dikkat çekmek amacıyla Dünya Antimikrobiyal Farkındalık Haftası (DAFH), kapsamında farklı platformlarda çalışmalar sürdürülüyor.
Antibiyotiklerin insanlık için en büyük buluşlardan biri olmakla birlikte gelinen noktada durumun hem bugün hem de gelecek için tehlikeli boyuta ulaştığını söyleyen Yeditepe Üniversitesi Hastaneleri Enfeksiyon Hastalıkları ve Klinik Mikrobiyoloji uzmanı Prof. Dr. Meral Sönmezoğlu, konuyla ilgili önemli açıklamalarda bulundu.

DAFH’nın bu yılki temasının “Antimikrobiyal Direnci Birlikte Önlemek” olduğunu belirten Prof. Dr. Sönmezoğlu, “Tüm sektörleri, antimikrobiyallerin dikkatli kullanımını teşvik etmeye ve “Tek Sağlık” yaklaşımıyla iş birliği içinde çalışarak antimikrobiyal direnci önlemeye yönelik tedbirleri güçlendirmeye çağırmıştır” diye konuştu.
ANTİBİYOTİKLERİN DOĞRU KULLANIMI ZORUNLU HALE GELDİ
“Araştırmalara göre, bakteri direncinin 2019’da yaklaşık 1,27 milyon kişinin hayatını kaybetmesine neden olduğu tahmin ediliyor” diyen Prof. Dr. Meral Sönmezoğlu, “Bu gerçeğin yanında büyük ekonomik kayıplar özellikle düşük ve orta gelir düzeyindeki ülkelerde büyük sorun haline gelmiştir. Yeni antibiyotik üretimi artık çok zor olduğu ve ufukta iyi haberler görünmediği için elimizdeki kullanılabilir antibiyotiklerin doğru yönetilmesi zorunlu olmuştur” diye konuştu.
SON 10 YILDA ÜLKEMİZDE ANTİBİYOTİK KULLANIM ORANI YAKLAŞIK YÜZDE 33 ORANINDA ARTTI
Dünya Sağlık Örgütü’nün antimikrobiyal direncin izlenmesi için (Global Antimicrobial Resistance Surveillance System (GLASS)) sürveyans sistemi ile alınacak kararların belirlenmeye başlandığını söyleyen Prof. Dr. Meral Sönmezoğlu şu bilgileri verdi:
”Öncelikle başlanan AWaRe isimli antibiyotik sınıflaması ile antibiyotik kullanımı kuralları belirlenmiş ve izlenmeye başlanmıştır. İnceleme ile alınan ilk sonuçlara göre ülkemizde antibiyotik kullanımı son 10 yılda yüzde 32.87 artmış ve ilk seçilecek antibiyotikler tüm antibiyotiklerin en az yüzde 60’ı olması gerekirken, ülkemizde bu oran yüzde 40’lardadır. Ayrıca ülkemiz antibiyotik direncinin en yüksek olduğu ülkeler arasında yer almaktadır.”
TÜRKİYE, ANTİBİYOTİK KULLANIM ORANI EN YÜKSEK ÜLKELER ARASINDA
Antibiyotik kullanımının, antimikrobiyal direncin (AMD) başlıca itici gücü olduğunun altını çizen Prof. Dr. Meral Sönmezoğlu, “Ne yazık ki ülkemiz antibiyotik tüketiminin DSÖ Avrupa Bölgesi genelinde en yüksek oranlar arasında. Bununla birlikte çözüm için Türkiye’de antibiyotik kullanımını izlemek ve kontrol etmek için yeni bir elektronik reçete sistemi geliştirilmiştir. Sistem reçete verilerini takip ederek hekime geri bildirim veriyor.”
ANTİBİYOTİK DİRENCİ NASIL KONTROL ALTINA ALINABİLİR?
Türkiye’nin DSÖ Antimikrobiyal İlaç Tüketim Ağı üyesi olduğunu ve verilerin de DSÖ uluslararası standartlarına uygun olduğunu da belirten Prof. Dr. Meral Sönmezoğlu, antibiyotik direncinin kontrol altına alınması için yapılması gerekenler konusunda şunları anlattı:
“Öncelikle antibiyotikler sadece doktor önerdiği zaman ve doktorun belirlediği sürede kullanılmalıdır. En fazla antibiyotik yazılan hastalık olan üst solunum yolu enfeksiyonlarının çoğu antibiyotiklerin etkili olduğu bakterilere değil virüslere bağlı olarak gelişir ve antibiyotikler hiç etki etmez.
Bununla birlikte hastaların ya da yakınlarının hekimlerine antibiyotik reçete etmesi için istekte bulunulmamalı. Evde antibiyotik bulundurulmamalı ve başkalarına antibiyotik önerilmemelidir. Antibiyotikler ateş düşürücü ve ağrı kesici olarak kullanılmamalıdır. En önemli noktalardan biri de antibiyotiklerin doğru sürede kullanımı. Önerildiği süreden önce antibiyotikler kesilmemeli ancak gereğinden uzun da kullanılmamalıdır.”












